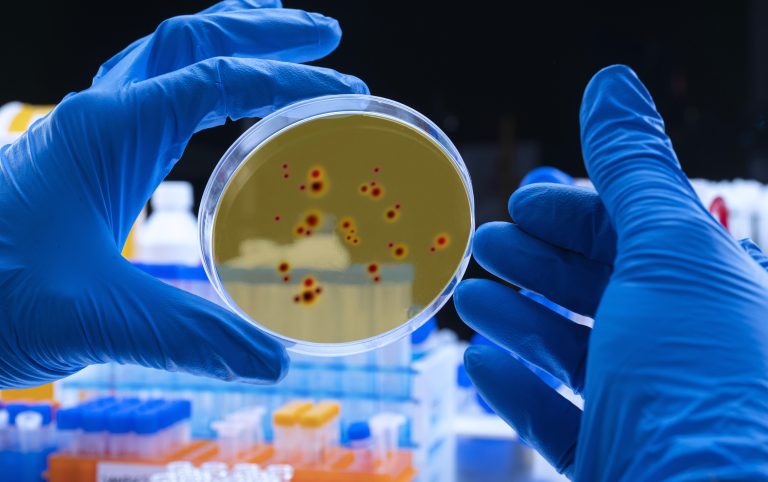

Brasil já registrou quatro casos de sorotipo 3, que não era diagnosticado desde 1996 no país
Por: Central Press
Depois de sete anos sem sorotipo 3 da dengue no Brasil, a Fundação Oswaldo Cruz (Fiocruz) identificou quatro casos de pessoas infectadas com esse tipo no país, um deles em Curitiba, no Paraná. Segundo a instituição, a doença foi importada, visto que a pessoa diagnosticada havia viajado para o Suriname, onde pode ter contraído a dengue. Os outros três casos foram autóctones do estado de Roraima, com pacientes que não tinham histórico de viagens.
Para o infectologista do Hospital São Marcelino Champagnat, Bernardo Almeida, a volta do sorotipo 3 acende o alerta para casos graves da doença. “A preocupação é porque essa cepa da dengue não circula intensamente há muito tempo e grande parte da população não possui imunidade para esse sorotipo. Com mais de uma cepa circulando, aumentam as chances de reinfecção e incidência de casos graves, comprovados pelos oito óbitos já registrados no Paraná”.
Fases da dengue
A dengue tem três estágios importantes que devem ser observados. O primeiro, chamado de febril, dura de três a sete dias e o principal sintoma é a febre, mas que vem acompanhado de dor de cabeça, no fundo dos olhos, vômito, dor no corpo, articular e eventualmente manchas na pele. A segunda fase é conhecida como crítica e nem todos chegam. Nela estão as manifestações hemorrágicas, sangramentos e choque, que é quando a pressão arterial cai a níveis críticos e dura normalmente três dias, mas pode chegar a mais tempo em pessoas que acabam internadas. A última fase é a de recuperação que dura de dois a quatro dias e é marcada pelo cansaço e fadiga.
“O momento certo de pessoas com suspeita de dengue procurarem um hospital é na segunda fase e pode ser monitorada pelo paciente ou cuidador. Principalmente, se surgirem dor abdominal intensa, vômito persistente e sangramentos nas fezes ou gengiva, grande irritabilidade e mais sono do que o normal e ainda quando tem queda na pressão mesmo deitado ou em pé”, explica o infectologista. “O tratamento é basicamente suporte com medicações como anti térmico e analgésicos, além de hidratação”, complementa.
Foto de Capa: Envato